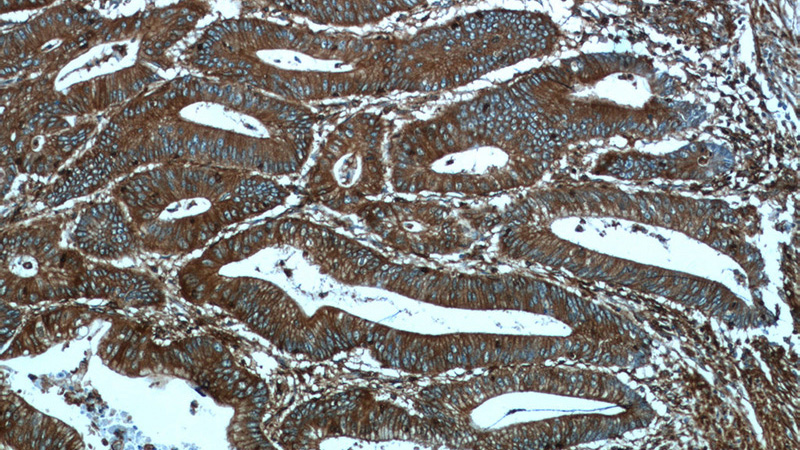
Immunohistochemistry of paraffin-embedded human colon cancer tissue slide using Catalog No:113503(PALLD,palladin Antibody) at dilution of 1:50 (under 10x lens)
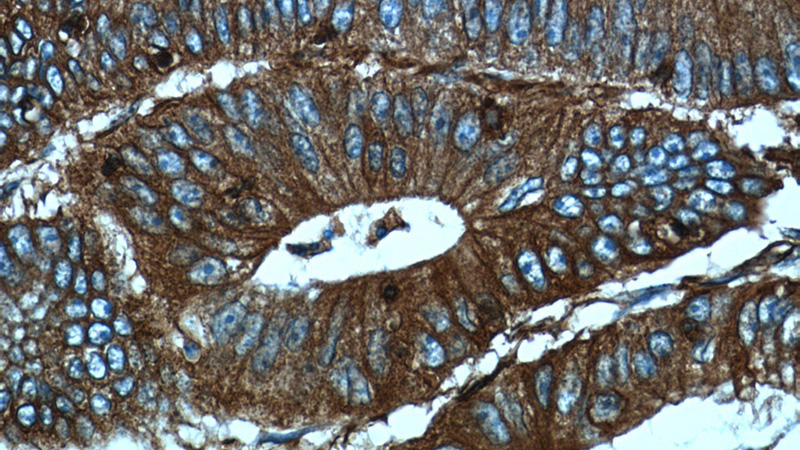
Immunohistochemistry of paraffin-embedded human colon cancer tissue slide using Catalog No:113503(PALLD,palladin Antibody) at dilution of 1:50 (under 40x lens)

-
Product Name
Palladin antibody
- Documents
-
Description
Palladin Rabbit Polyclonal antibody. Positive FC detected in HeLa cells. Positive IHC detected in human colon cancer tissue, human colon tissue, human ovary tumor tissue. Positive IF detected in HeLa cells. Positive WB detected in HeLa cells, A549 cells, HepG2 cells, mouse kidney tissue. Positive IP detected in HeLa cells, HEK-293 cells. Observed molecular weight by Western-blot: 95 kDa, 140 kDa
-
Tested applications
ELISA, WB, IP, IHC, FC, IF
-
Species reactivity
Human, Mouse; other species not tested.
-
Alternative names
CGI 151 antibody; FLJ22190 antibody; FLJ38193 antibody; FLJ39139 antibody; KIAA0992 antibody; palladin antibody; PALLD antibody; PNCA1 antibody; Sarcoma antigen NY SAR 77 antibody; SIH002 antibody
- Immunogen
-
Isotype
Rabbit IgG
-
Preparation
This antibody was obtained by immunization of Palladin recombinant protein (Accession Number: BC013867). Purification method: Antigen affinity purified.
-
Clonality
Polyclonal
-
Formulation
PBS with 0.1% sodium azide and 50% glycerol pH 7.3.
-
Storage instructions
Store at -20℃. DO NOT ALIQUOT
-
Applications
Recommended Dilution:
WB: 1:1000-1:10000
IP: 1:1000-1:10000
IHC: 1:20-1:200
IF: 1:20-1:200
-
Validations

A549 cells (shcontrol and shRNA of PALLD) were subjected to SDS PAGE followed by western blot with Catalog No:113503 (PALLD antibody) at dilution of 1:2000. (Data provided by Angran Biotech (www.miRNAlab.com)).
Immunohistochemistry of paraffin-embedded human colon cancer tissue slide using Catalog No:113503(PALLD,palladin Antibody) at dilution of 1:50 (under 10x lens)

IP Result of anti-PALLD,palladin (IP:Catalog No:113503, 4ug; Detection:Catalog No:113503 1:2000) with HeLa cells lysate 1800ug.

HeLa cells were subjected to SDS PAGE followed by western blot with Catalog No:113503(PALLD,palladin antibody) at dilution of 1:2000
Immunohistochemistry of paraffin-embedded human colon cancer tissue slide using Catalog No:113503(PALLD,palladin Antibody) at dilution of 1:50 (under 40x lens)

Immunofluorescent analysis of HeLa cells using Catalog No:113503(PALLD,palladin Antibody) at dilution of 1:50 and Alexa Fluor 488-congugated AffiniPure Goat Anti-Rabbit IgG(H+L)

1X10^6 HeLa cells were stained with 0.2ug PALLD,palladin antibody (Catalog No:113503, red) and control antibody (blue). Fixed with 4% PFA blocked with 3% BSA (30 min). Alexa Fluor 488-congugated AffiniPure Goat Anti-Rabbit IgG(H+L) with dilution 1:1000.
-
Background
Palladin is an actin associated protein serving as a cytoskeleton scaffold, and actin cross linker, localizing at stress fibers, focal adhesions, and other actin based structures. Palladin exists as multiple isoforms through alternative transcription initiation sites and splicing. There are three major isoforms (200, 140, 90-92 kDa) and multiple minor isoforms. Different palladin isoforms are expressed in a tissue-specific pattern during development and in adult organs: the 200 kDa isoform is predominantly expressed in the heart, skeletal muscle, testis and bone; the 140 kDa isoform is widely expressed with the exception of liver, muscle, and skin; the 90-92 kDa isoform is broadly expressed in embryonic tissues and highly expressed in adult smooth muscle tissues (21455759). Recently overexpression of palladin has been linked to the promoted invasive motility in several types of cancers (18978809, 22291919). The 85-90 kDa palladin isoform has been observed predominantly expressed in pancreatic ductal adenocarcinoma (PDA) while a 65 kDa isoform is expressed in normal pancreas and non-PDA tumors (20436683). This antibody, generated against the fragment 999-1383aa of palladin, recognizes most isoforms of this protein, except isoform 6.
-
References
- Qian X, Mruk DD, Wong EW, Lie PP, Cheng CY. Palladin is a regulator of actin filament bundles at the ectoplasmic specialization in adult rat testes. Endocrinology. 154(5):1907-20. 2013.
- Nguyen NU, Liang VR, Wang HV. Actin-associated protein palladin is required for migration behavior and differentiation potential of C2C12 myoblast cells. Biochemical and biophysical research communications. 452(3):728-33. 2014.
- Nguyen NU, Wang HV. Dual roles of palladin protein in in vitro myogenesis: inhibition of early induction but promotion of myotube maturation. PloS one. 10(4):e0124762. 2015.
- Li N, Mruk DD, Wong CK, Han D, Lee WM, Cheng CY. Formin 1 Regulates Ectoplasmic Specialization in the Rat Testis Through Its Actin Nucleation and Bundling Activity. Endocrinology. 156(8):2969-83. 2015.
- Watarai A, Schirmer L, Thönes S. TGFβ functionalized starPEG-heparin hydrogels modulate human dermal fibroblast growth and differentiation. Acta biomaterialia. 25:65-75. 2015.
- Cannon AR, Owen MK, Guerrero MS. Palladin expression is a conserved characteristic of the desmoplastic tumor microenvironment and contributes to altered gene expression. Cytoskeleton (Hoboken, N.J.). 72(8):402-11. 2015.
- Li N, Mruk DD, Wong CK, Lee WM, Han D, Cheng CY. Actin-bundling protein plastin 3 is a regulator of ectoplasmic specialization dynamics during spermatogenesis in the rat testis. FASEB journal : official publication of the Federation of American Societies for Experimental Biology. 29(9):3788-805. 2015.
- He J, Huang L, Qiu H. A new design of a lentiviral shRNA vector with inducible co-expression of ARGONAUTE 2 for enhancing gene silencing efficiency. Cell & bioscience. 5:67. 2015.
Related Products / Services
Please note: All products are "FOR RESEARCH USE ONLY AND ARE NOT INTENDED FOR DIAGNOSTIC OR THERAPEUTIC USE"
